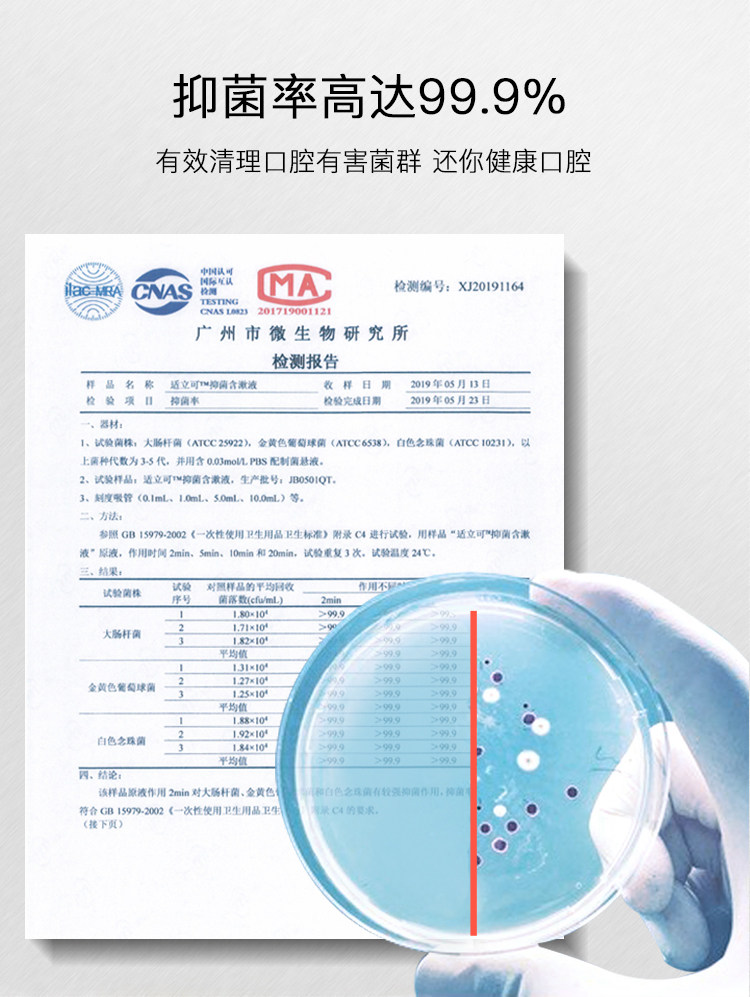

适立可 Медицинское ртутное хлор имеет фиксированную стерилизацию стерилизации и дезодорантовые зубные камни, камни, экстракция зубов мудрости, отеки десен и боль беременные женщины

Цена: 968-1 936руб. (¥45.8)
Артикул: 619235198219
Вес товара: ~0.7 кг. Указан усредненный вес, который может отличаться от фактического. Не включен в цену, оплачивается при получении.
Описание товараPGRpdj48aW1nIHNyYz0iaHR0cHM6Ly9pbWcuYWxpY2RuLmNvbS9pbWdleHRyYS9pNC8yMjA3OTIyNDAyOTcyL08xQ04wMUlWYVZOUTFYcERtRGNlcHNNXyEhMjIwNzkyMjQwMjk3Mi5qcGciPjwvZGl2PjxkaXY+PGltZyBzcmM9Imh0dHBzOi8vaW1nLmFsaWNkbi5jb20vaW1nZXh0cmEvaTQvMjIwNzkyMjQwMjk3Mi9PMUNOMDEwSU9KcFUxWHBEbVFNT3BIeF8hITIyMDc5MjI0MDI5NzIuanBnIj48L2Rpdj48ZGl2PjxpbWcgc3JjPSJodHRwczovL2ltZy5hbGljZG4uY29tL2ltZ2V4dHJhL2kxLzIyMDc5MjI0MDI5NzIvTzFDTjAxMUxvaHJKMVhwRG50V2hTUGdfISEyMjA3OTIyNDAyOTcyLmpwZyI+PC9kaXY+PGRpdj48aW1nIHNyYz0iaHR0cHM6Ly9pbWcuYWxpY2RuLmNvbS9pbWdleHRyYS9pMy8yMjA3OTIyNDAyOTcyL08xQ04wMU1tdXNYUDFYcERodkYyajdRXyEhMjIwNzkyMjQwMjk3Mi5qcGciPjwvZGl2PjxkaXY+PGltZyBzcmM9Imh0dHBzOi8vaW1nLmFsaWNkbi5jb20vaW1nZXh0cmEvaTQvMjIwNzkyMjQwMjk3Mi9PMUNOMDFCN0prZGYxWHBEaTB1ZUxBdV8hITIyMDc5MjI0MDI5NzIucG5nIj48L2Rpdj48ZGl2PjxpbWcgc3JjPSJodHRwczovL2ltZy5hbGljZG4uY29tL2ltZ2V4dHJhL2k0LzIyMDc5MjI0MDI5NzIvTzFDTjAxQURETGZqMVhwRGk1TzVDZkpfISEyMjA3OTIyNDAyOTcyLmpwZyI+PC9kaXY+PGRpdj48aW1nIHNyYz0iaHR0cHM6Ly9pbWcuYWxpY2RuLmNvbS9pbWdleHRyYS9pMS8yMjA3OTIyNDAyOTcyL08xQ04wMUdGZ1BNRjFYcERpMHVoMVN3XyEhMjIwNzkyMjQwMjk3Mi5qcGciPjwvZGl2PjxkaXY+PGltZyBzcmM9Imh0dHBzOi8vaW1nLmFsaWNkbi5jb20vaW1nZXh0cmEvaTIvMjIwNzkyMjQwMjk3Mi9PMUNOMDE2bXdZSm4xWHBEaTc3QzE1RV8hITIyMDc5MjI0MDI5NzIuanBnIj48L2Rpdj48ZGl2PjxpbWcgc3JjPSJodHRwczovL2ltZy5hbGljZG4uY29tL2ltZ2V4dHJhL2kyLzIyMDc5MjI0MDI5NzIvTzFDTjAxVGZUM0d5MVhwRGkxSzFkYkZfISEyMjA3OTIyNDAyOTcyLmpwZyI+PC9kaXY+PGRpdj48aW1nIHNyYz0iaHR0cHM6Ly9pbWcuYWxpY2RuLmNvbS9pbWdleHRyYS9pMS8yMjA3OTIyNDAyOTcyL08xQ04wMUtuTXBjajFYcERpNzdFUW1UXyEhMjIwNzkyMjQwMjk3Mi5qcGciPjwvZGl2PjxkaXY+PGltZyBzcmM9Imh0dHBzOi8vaW1nLmFsaWNkbi5jb20vaW1nZXh0cmEvaTIvMjIwNzkyMjQwMjk3Mi9PMUNOMDFZcFYzdk8xWHBEaTc3RFFQZl8hITIyMDc5MjI0MDI5NzIuanBnIj48L2Rpdj48ZGl2PjxpbWcgc3JjPSJodHRwczovL2ltZy5hbGljZG4uY29tL2ltZ2V4dHJhL2kxLzIyMDc5MjI0MDI5NzIvTzFDTjAxUlpkcVFCMVhwRGkycWduaW1fISEyMjA3OTIyNDAyOTcyLmpwZyI+PC9kaXY+PGRpdj48aW1nIHNyYz0iaHR0cHM6Ly9pbWcuYWxpY2RuLmNvbS9pbWdleHRyYS9pMS8yMjA3OTIyNDAyOTcyL08xQ04wMXg1TVRxZDFYcERodkYzcnAwXyEhMjIwNzkyMjQwMjk3Mi5qcGciPjwvZGl2PjxkaXY+PGltZyBzcmM9Imh0dHBzOi8vaW1nLmFsaWNkbi5jb20vaW1nZXh0cmEvaTEvMjIwNzkyMjQwMjk3Mi9PMUNOMDFLbkxFS0ExWHBEaTRuQ254TF8hITIyMDc5MjI0MDI5NzIuanBnIj48L2Rpdj48ZGl2PjxpbWcgc3JjPSJodHRwczovL2ltZy5hbGljZG4uY29tL2ltZ2V4dHJhL2k0LzIyMDc5MjI0MDI5NzIvTzFDTjAxRUFNajVmMVhwRGk3cFREMlNfISEyMjA3OTIyNDAyOTcyLmpwZyI+PC9kaXY+PGRpdj48aW1nIHNyYz0iaHR0cHM6Ly9pbWcuYWxpY2RuLmNvbS9pbWdleHRyYS9pMS8yMjA3OTIyNDAyOTcyL08xQ04wMXRTU0R4WTFYcERsUHptVXNnXyEhMjIwNzkyMjQwMjk3Mi5qcGciPjwvZGl2PjxkaXY+PGltZyBzcmM9Imh0dHBzOi8vaW1nLmFsaWNkbi5jb20vaW1nZXh0cmEvaTQvMjIwNzkyMjQwMjk3Mi9PMUNOMDFOWXNpRU0xWHBEbGNqSVpyRl8hITIyMDc5MjI0MDI5NzIuanBnIj48L2Rpdj48ZGl2PjxpbWcgc3JjPSJodHRwczovL2ltZy5hbGljZG4uY29tL2ltZ2V4dHJhL2kxLzIyMDc5MjI0MDI5NzIvTzFDTjAxRUF2WHk4MVhwRGxaNlFoQm1fISEyMjA3OTIyNDAyOTcyLmpwZyI+PC9kaXY+
Продавец:信而富医疗器械专营店
Рейтинг:

Всего отзывов:0
Положительных:0
Выберите вариацию / цвет
Добавить в корзину
- Информация о товаре
- Фотографии
| Цвет: | Антибактериальный ополаскиватель для рта, 240 мл, Антибактериальный ополаскиватель для рта, 240 мл |